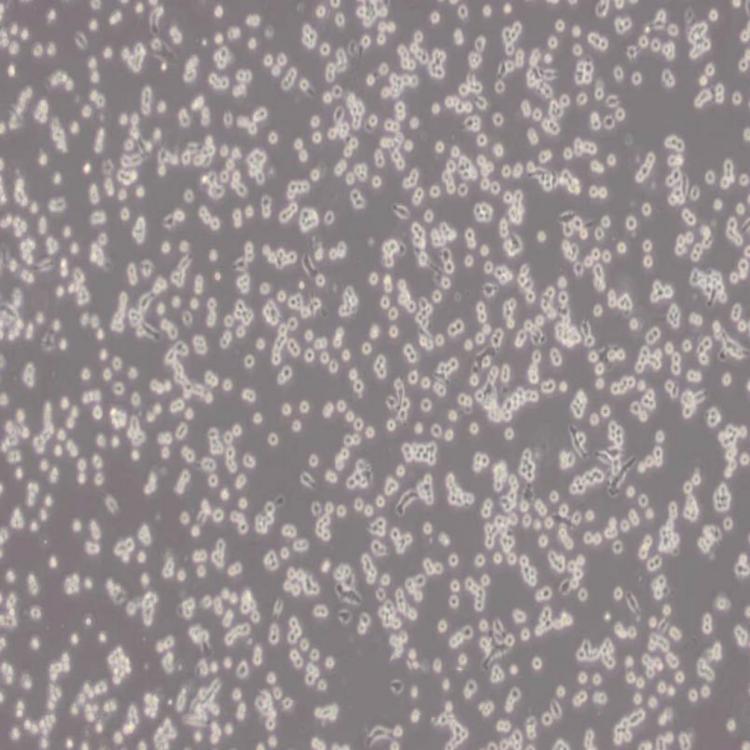
BNL CL.2细胞_小鼠胚胎肝细胞

相关产品推荐更多 >
万千商家帮你免费找货
0 人在求购买到急需产品
- 详细信息
- 技术资料
- 品系:
细胞系
- 细胞类型:
自发永生化细胞
- 供应商:
上海机纯实业有限公司
- 库存:
大量
- 生长状态:
贴壁细胞
- 年限:
5年
- 运输方式:
快递包邮
- 细胞形态:
成纤维细胞样
- 组织来源:
肝
- 英文名:
BNL CL.2
- 规格:
T25培养瓶
BNL CL.2细胞_小鼠胚胎肝细胞
BNCL-2_小鼠胚胎肝细胞背景描述:BNCL-2细胞是在用鸟氨酸和苯丙氨酸代替精氨酸和酪氨酸的平板上选择建立的细胞株;检测表明,BNCL-2细胞肢骨发育畸形病毒(鼠痘)阴性。

别 称:BNL-CL.2; BNL CL2; BNL.CL2; BN-CL2; BNCL-2; BNCL2
种 属:小鼠
组织来源:肝
生长特性:贴壁细胞
细胞形态:成纤维细胞样
细胞类型:自发永生化细胞
生物安全等级:1
生长培养基:DMEM+10% FBS+1% P/S
推荐传代比例:1:2-1:4
推荐换液频率:2~3次/周
冻存条件:
冻存液:55% 基础培养基+40%FBS+5%DMSO
温 度:液氮

BNL CL.2细胞_小鼠胚胎肝细胞培养条件:
气 相:空气,95%;CO2,5%
温 度:37℃
致瘤性:No, the cells were not tumorigenic in immunosuppressed mice, but did form colonies in semisolid medium.
保藏机构:ATCC; TIB-73 BCRC; 60180
BNCL-2_小鼠胚胎肝细胞背景描述:BNCL-2细胞是在用鸟氨酸和苯丙氨酸代替精氨酸和酪氨酸的平板上选择建立的细胞株;检测表明,BNCL-2细胞肢骨发育畸形病毒(鼠痘)阴性。
别 称:BNL-CL.2; BNL CL2; BNL.CL2; BN-CL2; BNCL-2; BNCL2
种 属:小鼠
组织来源:肝
生长特性:贴壁细胞
细胞形态:成纤维细胞样
细胞类型:自发永生化细胞
生物安全等级:1
生长培养基:DMEM+10% FBS+1% P/S
推荐传代比例:1:2-1:4
推荐换液频率:2~3次/周
冻存条件:
冻存液:55% 基础培养基+40%FBS+5%DMSO
温 度:液氮

BNL CL.2细胞_小鼠胚胎肝细胞培养条件:
气 相:空气,95%;CO2,5%
温 度:37℃
致瘤性:No, the cells were not tumorigenic in immunosuppressed mice, but did form colonies in semisolid medium.
保藏机构:ATCC; TIB-73 BCRC; 60180
风险提示:丁香通仅作为第三方平台,为商家信息发布提供平台空间。用户咨询产品时请注意保护个人信息及财产安全,合理判断,谨慎选购商品,商家和用户对交易行为负责。对于医疗器械类产品,请先查证核实企业经营资质和医疗器械产品注册证情况。
BNL CL.2细胞_小鼠胚胎肝细胞
¥1200










